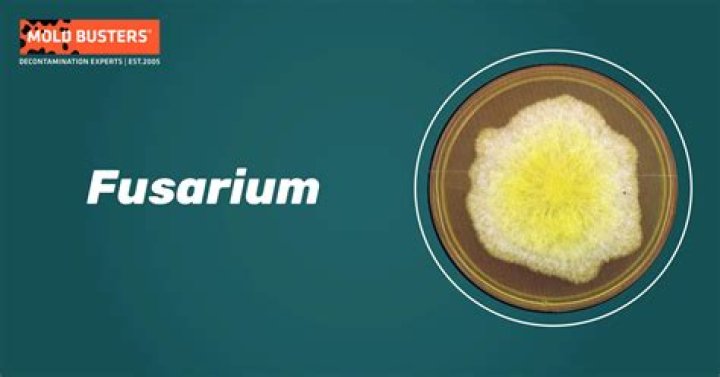

How do humans get Fusarium
Fusarium species are ubiquitous and may be found in the soil, air and on plants. Fusarium species can cause mycotoxicosis in humans following ingestion of food that has been colonized by the fungal organism. In humans, Fusarium species can also cause disease that is localized, focally invasive or disseminated.
How do I get rid of Fusarium?
- Treat seed with a fungicide or heat to destroy the fungus on the seed and to protect the emerging seedlings from infection.
- Dip bulbs and corms in fungicide or hot water (or both) to reduce Fusarium.
Where does Fusarium come from?
fusarium wilt, widespread plant disease caused by many forms of the soil-inhabiting fungus Fusarium oxysporum. Several hundred plant species are susceptible, including economically important food crops such as sweet potatoes, tomatoes, legumes, melons, and bananas (in which the infection is known as Panama disease).
Is fusarium wilt airborne?
Fusarium oxysporum f. spp. have been shown to enter greenhouses by airborne inoculum. Rowe et al. (1977) reported that airborne microconidia of F.How do Mycotoxins affect humans?
Mycotoxins can cause a variety of adverse health effects and pose a serious health threat to both humans and livestock. The adverse health effects of mycotoxins range from acute poisoning to long-term effects such as immune deficiency and cancer.
How do you prevent Fusarium?
- Remove or destroy crop residues.
- Choose resistant cultivars.
- Use clean propagation materials (seed can be treated effectively with hot water)
- Use clean substrate in greenhouse crops.
- Disinfect tools, machinery and irrigation water in greenhouses.
- Prevent stress for the plants.
What is a Fusarium infection?
Fusarium species, in particular, Fusarium solani, are common causes of keratitis. They are also common causes of onychomycosis, endophthalmitis, and skin and musculoskeletal infections. The disseminated form of infection most commonly occurs in patients with acute leukemia and prolonged neutropenia.
How do you treat Fusarium in soil?
Simply remove the soil from around the roots, bulb, corm, or tuber and rinse completely. Then soak the roots or storage organs in a bucket of fresh water with the appropriate amount of a fungicide. Controlling Fusarium fungus in the garden relies upon crop rotations and clean, sanitary practices.How do you get rid of Phytophthora in soil?
Steam heat is effective to kill Phytophthora in contaminated soil, media or on planting containers such as pots. If you re-use pots you can soak pre-cleaned pots in hot (180°F) water for at least 30 min or use aerated steam (140°F) for 30 min.
How common is fusarium wilt?Fusarium wilt can be seed borne, but it is rare in commercial seed. The fungus can be introduced on infected transplants or spread on equipment contaminated with infested soil.
Article first time published onDoes Fusarium affect all plants?
Fusarium wilt affects many plant types, but tomato gardeners know this deadly, soil-borne disease especially well. Also known as stem rot, it’s a common tomato wilt disease, which moves into plants through their roots.
What does fusarium wilt do to bananas?
This opens in a new window. Fusarium wilt is a typical vascular wilt disease. The fungus invades the vascular tissue through the roots causing discolouration and wilting, eventually killing the plant.
What foods contain Fusarium?
Wheat and maize are the most significant sources of Fusarium mycotoxin contamination.
What fungicide kills Fusarium?
Fungicide use is recommended as part of an IPM program to manage Fusarium head blight. Tebuconazole has been used in many states to suppress this disease since the 1990s. Currently, the most effective fungicides use metaconazole or a prothioconazole, or a combination of prothioconazole and tebuconazole.
Is Fusarium a pest?
Fusarium is a large genus of soil fungi widely distributed in the world. Most species are harmless saprobes and are relatively abundant members of the soil microbial community. nonetheless, some Fusarium species are economically important due to their devastating impact on crops.
Are mycotoxins airborne?
Toxins from household fungi can easily become airborne and cause health problems, a new study has found. … “Thus, mycotoxins can be inhaled and should be investigated as parameters of indoor air quality, especially in homes with visible fungal contamination.”
Are mycotoxins contagious?
Mycotoxicoses occur when mycotoxins enter the body, usually by consumption of contaminated feed. Ill health is caused by actions of mycotoxins on cells in the body. Mycotoxicoses are not contagious, nor is there significant stimulation of the immune system.
How can I get mycotoxins out of my body?
I also recommend liver detox support like glutathione, NAC, milk thistle, minerals, vitamin C and the B vitamins. Sweating via exercise or a sauna is another great way to reduce mycotoxin levels in the body. Although air filters in the home can drastically reduce the level of mycotoxins, they are not a permanent fix.
Can humans get Fusarium?
In humans, Fusarium species cause a broad spectrum of infections, including superficial (such as keratitis and onychomycosis), locally invasive, or disseminated infections, with the last occurring almost exclusively in severely immunocompromised patients (74).
Is Aspergillus contagious to humans?
But people who have a weakened immune system from illness or immunosuppressant medications have fewer infection-fighting cells. This allows aspergillus to take hold, invading the lungs and, in the most serious cases, other parts of the body. Aspergillosis is not contagious from person to person.
How does Fusarium wilt spread?
This pathogen spreads in two basic ways: it spreads short distances by water splash, and by planting equipment, and long distances by infected transplants and seeds. F. oxysporum infects a healthy plant by means of mycelia or by germinating spores penetrating the plant’s root tips, root wounds, or lateral roots.
How long does Phytophthora live in soil?
Species of Phytophthora produce resting spores that survive for years in moist soil in the absence of a suitable host. However, if the soil is completely dried out, these spores are less likely to survive for more than a few months.
How do you spot Phytophthora?
- Large irregular brown spots form on leaves.
- Stem and leaf petiole lesions are light to dark brown, water soaked and irregular.
- Leaves wilt and the entire plant may collapse if root and crown rot occurs. …
- Fruit develop soft, water-soaked rot.
Can plants recover from Phytophthora?
Mildly infected plants may recover if the soil is allowed to dry out.
Can you eat tomatoes from a plant with Fusarium wilt?
If the plant appears to be in the throes of the disease, but there are multitudes of green, seemingly unaffected green fruit, you may be wondering if you can ripen tomatoes with blight. Yes, you can try.
How do you control the fusarium wilt in a banana?
In the same study, it was found that the disease symptoms of Fusarium wilt can be controlled up to 80.6% when benomyl and the demethylation-inhibiting fungicide were applied via root dip treatment. Besides, certain quaternary ammonium compounds were also reported as potent sterilants against Foc [78].
Does Panama disease affect other plants?
Does Panama disease TR4 affect any other fruit plants? No, Panama disease TR4 does not affect other fruit crops; however, it infects most banana varieties including the main commercial variety Cavendish.
Do bananas have a disease?
Nearly all of the bananas sold globally are just one kind called the Cavendish, which is susceptible to a deadly fungus called Tropical Race 4, or Panama Disease.
What are the symptoms of mycotoxins?
- Cognitive difficulties (e.g. brain fog, poor memory/concentration, anxiety)
- Pain (especially abdominal pain, but can include muscle pain similar to fibromyalgia)
- Unexplained weight gain or weight loss.
- Numbness and tingling in extremities or other areas of the body.
What foods have the most mycotoxins?
- Grains (including corn, wheat, barley and rye)
- Alcoholic beverages.
- Nuts (including peanuts, pistachios and Brazil nuts)
- Sugar (sugar cane and sugar beets)
- Hard cheeses.
- Coffee beans.
- Chocolate.
- Dried fruit.
What foods cause mycotoxins?
Mycotoxins appear in almost all kinds of animal feed and products such as wheat bran, noug cake, pea hulls, maize grain, milk and meat, and also human food such as cereal, fruit and vegetables, spice, etc. [5]. Consuming these foods creates serious health risks in human and all animal species.



